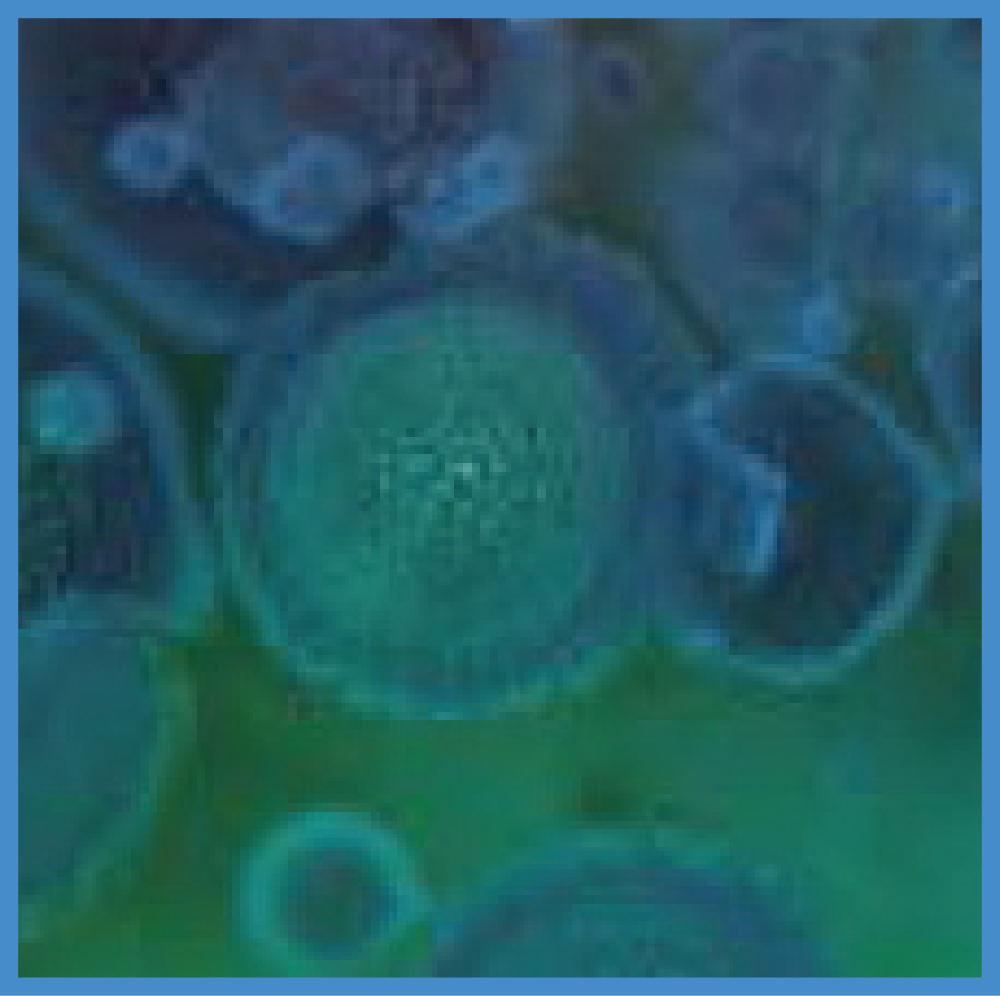
Empty heading

Mitsubishi Electric MSZ LN60VGR Red 22.000 BTU/h Κλιματιστικό Inverter
Λαμπερός και πολυτελής σχεδιασμός Σχεδιασμένη να συμπληρώνει τη σύγχρονη διακόσμηση εσωτερικών χώρων, η σειρά LN διατίθεται σε τρία χρώματα ειδικά... Read more
€1.983,00 €1.656,00
-
100% Ασφάλεια Συναλλαγών
- Δωρεάν αποστολή για αγορές άνω των €150
- Δωρεάν επιστροφή & αλλαγή εντός 14 ημερών
- Αποστολή σε 12 χώρες εντός Ε.Ε.